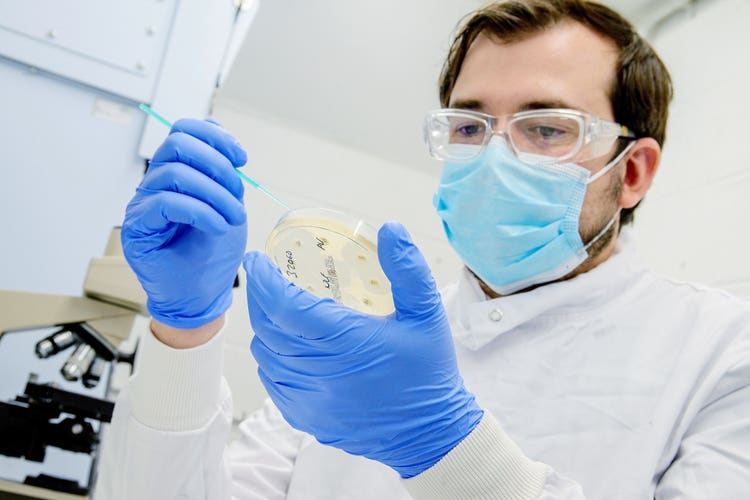

About Us
3xl
right-aligned
Veterinary Practices
Our first-opinion and referral practices provide specialist treatment for companion, equine and farm animals. We provide high-quality healthcare either when required, or through our preventative healthcare schemes: The Healthy Pet Club (HPC) and Horse Health Programme (HHP). We also operate buying groups and a veterinary consumable business, "Vet Direct”, and we supply a number of own-brand medicines and products.
Our Veterinary Practices

left
white
Laboratories
Our laboratories provide diagnostic services to CVS veterinary practices and third parties. We offer an extensive range of tests with the ability to tailor specific profiles to our customers’ needs. Our team of pathologists and experts specialise in a variety of disciplines in all areas of the laboratory, and their aim is to offer a level of service and expertise beyond our customers’ expectations.
Our Laboratories
right
white
Online Retail Business
Our online retail business, “Animed Direct”, sells prescription and non-prescription medicines, premium pet foods and an ever-increasing range of pet care products, which can be delivered directly to our customers’ doors.
Our Online Retail Business

left
white